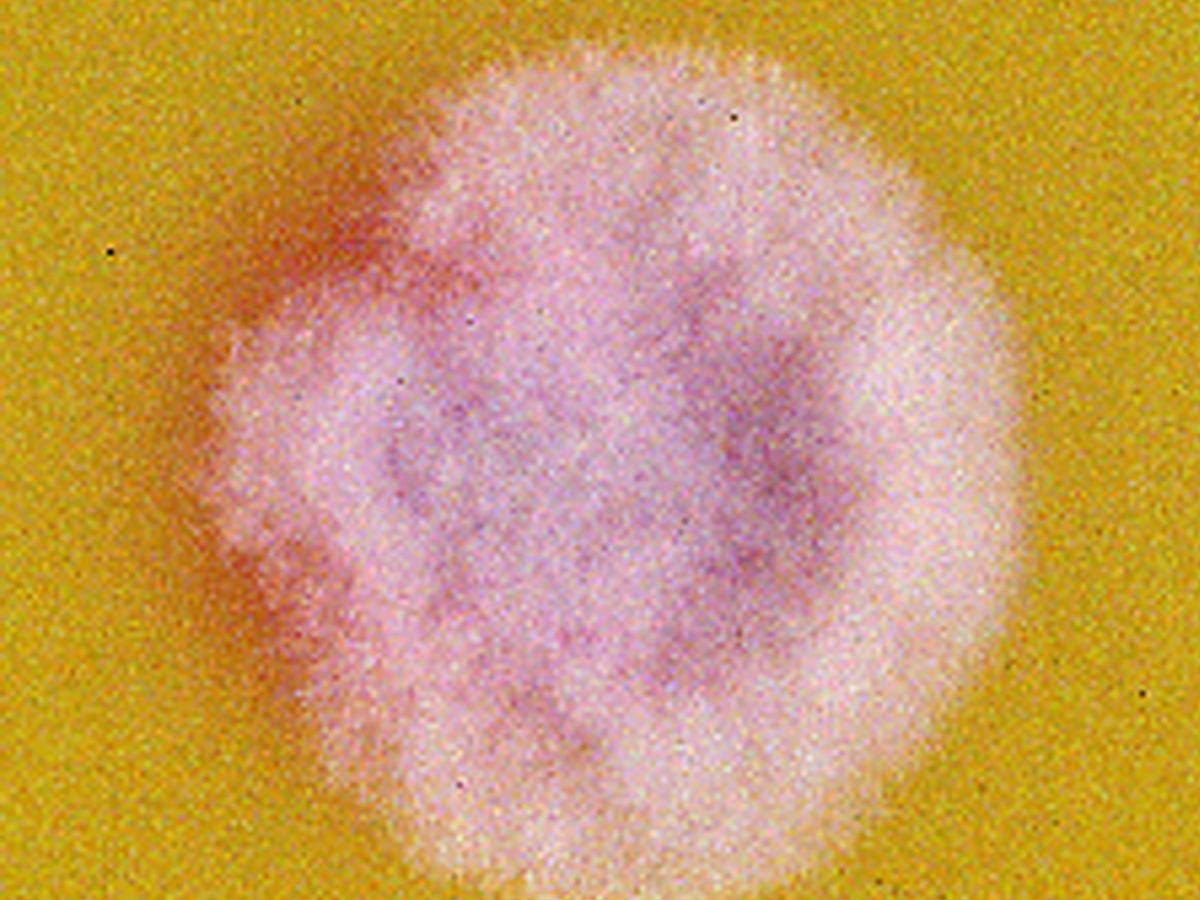
Culture

Status message
Correct! Excellent, you have really done well. Please find additional information below.
Unknown 14 = Fusarium solani complex
Direct microscopy (Lactophenol Cotton Blue Stain): Direct wet mount showing hyaline septate fungal hyphae.

Culture: Culture of Fusarium solani complex.
Microscopy: Microconidia of Fusarium solani complex are usually abundant, cylindrical to oval, 1- to 2-celled and formed from long lateral phialides.

Macroconidia Fusarium solani complex are formed after 4-7 days from short multi-branched conidiophores which may form sporodochia. They are 3- to 5-septate (usually 3-septate), fusiform, cylindrical, often moderately curved, with an indistinctly pedicellate foot cell and a short blunt apical cell.

Chlamydoconidia Fusarium solani complex are hyaline, globose, smooth- to rough-walled, borne singly or in pairs on short lateral hyphal branches, or they are intercalary.

Comment: The Fusarium solani complex contains at least 60 species and accounts for about 50% of human infections caused by fusaria. All are ubiquitous soil borne pathogens responsible for vascular wilts, rots, and damping-off diseases of a broad range of plants. A number of these fusaria, notably F. keratoplasticum, F. petroliphilum, F. lichenicola and F. solani are clinically important, causing localised or deeply invasive life threatening infections in humans and other animals. Note: Cylindrocarpon differs from Fusarium by lacking an asymmetrical foot-cell on the macroconidia. Sequencing of EF-1α, RPB1 and/or RPB2 is required for accurate identification of Fusarium species.
About Fusarium Back to virtual assessment